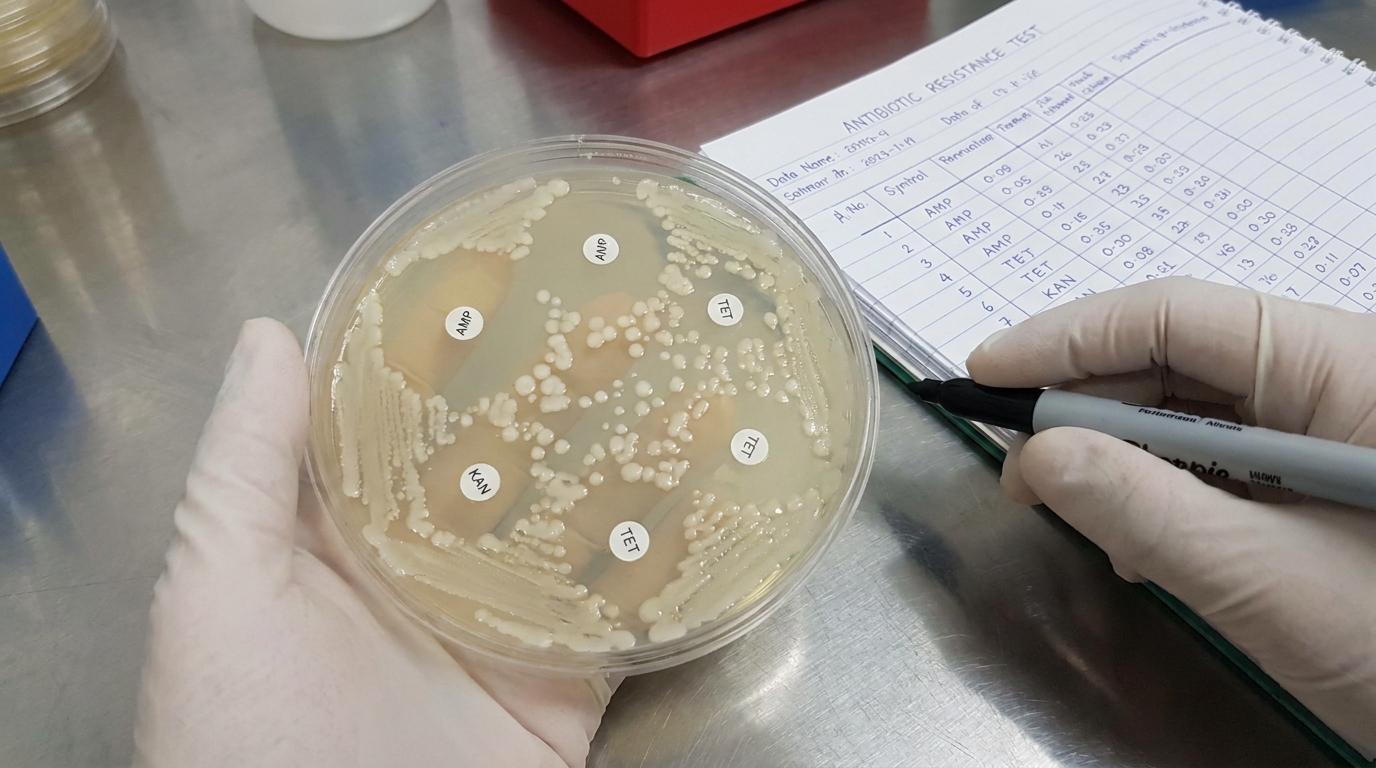
Bactérias preservadas no gelo milenar revelam mecanismos de defesa desenvolvidos naturalmente muito antes dos antibióticos modernos.

Cientistas extraem uma bactéria com mais de 5.000 anos do gelo e descobrem algo perturbador: ela já era resistente a dez antibióticos modernos muito antes da existência do nosso remédio
Conheça os detalhes da bactéria milenar que já possuía resistência a antibióticos muito antes da medicina moderna
A descoberta de microrganismos preservados sob camadas profundas de gelo milenar traz revelações que desafiam a compreensão humana sobre a evolução da vida microscópica. Recentemente, pesquisadores identificaram uma bactéria de cinco mil anos que já possuía mecanismos de defesa contra medicamentos modernos muito antes da invenção da medicina atual. Esse fenômeno demonstra que a complexidade biológica e a sobrevivência em ambientes extremos criaram barreiras naturais extremamente resilientes ao longo dos milênios.

Como microrganismos tão antigos conseguem manter sua integridade no gelo?
O permafrost atua como uma cápsula do tempo perfeita para a vida microscópica devido às suas temperaturas negativas constantes e ausência de oxigênio em camadas profundas. Essas condições permitem que o material genético e as estruturas celulares permaneçam preservados por milhares de anos sem sofrer a degradação comum em climas mais quentes.
A análise dessas amostras revela que a vida encontra caminhos para entrar em um estado de dormência profunda, aguardando condições favoráveis para retomar sua atividade biológica. Esse processo de criopreservação natural é um dos maiores mistérios da biologia moderna, permitindo o estudo direto de linhagens que existiram muito antes da civilização tecnológica.
De que maneira a resistência natural evoluiu sem o contato com remédios?
A ideia de que as bactérias desenvolvem defesas apenas em resposta ao uso excessivo de remédios humanos está sendo questionada por novas evidências laboratoriais. A competição feroz por recursos em nichos ecológicos limitados forçou esses seres a criarem defesas químicas poderosas para garantir sua própria sobrevivência e domínio territorial.

Diversos mecanismos genéticos são utilizados por esses microrganismos para neutralizar ameaças externas, demonstrando uma sofisticação bioquímica que já estava presente há milênios. As listas a seguir detalham alguns dos principais fatores que contribuem para essa imunidade ancestral encontrada no gelo profundo:
- Produção de enzimas capazes de degradar substâncias tóxicas.
- Bombas de efluxo que expulsam agentes invasores das células.
- Alterações nas proteínas de membrana para evitar a penetração de compostos.
Por que a descoberta dessa bactéria preocupa a comunidade de pesquisadores?
O fato de uma bactéria isolada há cinco mil anos ser imune a dez tipos de antibióticos modernos sugere que o arsenal terapêutico atual pode ser mais limitado do que se imaginava. Isso indica que as defesas bacterianas são parte integrante da evolução biológica, existindo de forma latente na natureza muito antes da intervenção humana direta.
Esse cenário levanta alertas sobre o descongelamento das regiões polares, que pode liberar patógenos antigos para os quais o sistema imunológico contemporâneo não possui preparo prévio. O monitoramento dessas áreas torna-se vital para prever possíveis crises sanitárias e entender a dinâmica de dispersão desses agentes infecciosos milenares.
Quais são as possíveis consequências do degelo para o equilíbrio biológico?
É fundamental investir em pesquisas que mapeiem a diversidade microbiológica escondida no gelo para antecipar mudanças significativas na saúde pública e ambiental. Alguns dos riscos associados a esse processo de transformação ecológica incluem os pontos listados abaixo:
- Ressurgimento de vírus e bactérias considerados extintos pela ciência atual.
- Alteração na composição de nutrientes e microrganismos nos oceanos globais.
- Surgimento de novas linhagens resistentes sem qualquer pressão seletiva humana.
A liberação de material genético antigo nos ecossistemas atuais pode acelerar a transferência horizontal de genes entre diferentes espécies de microrganismos presentes no solo e na água. Essa troca de informações biológicas tem o potencial de fortalecer cepas existentes, tornando o controle de infecções um desafio cada vez mais complexo para as futuras gerações.